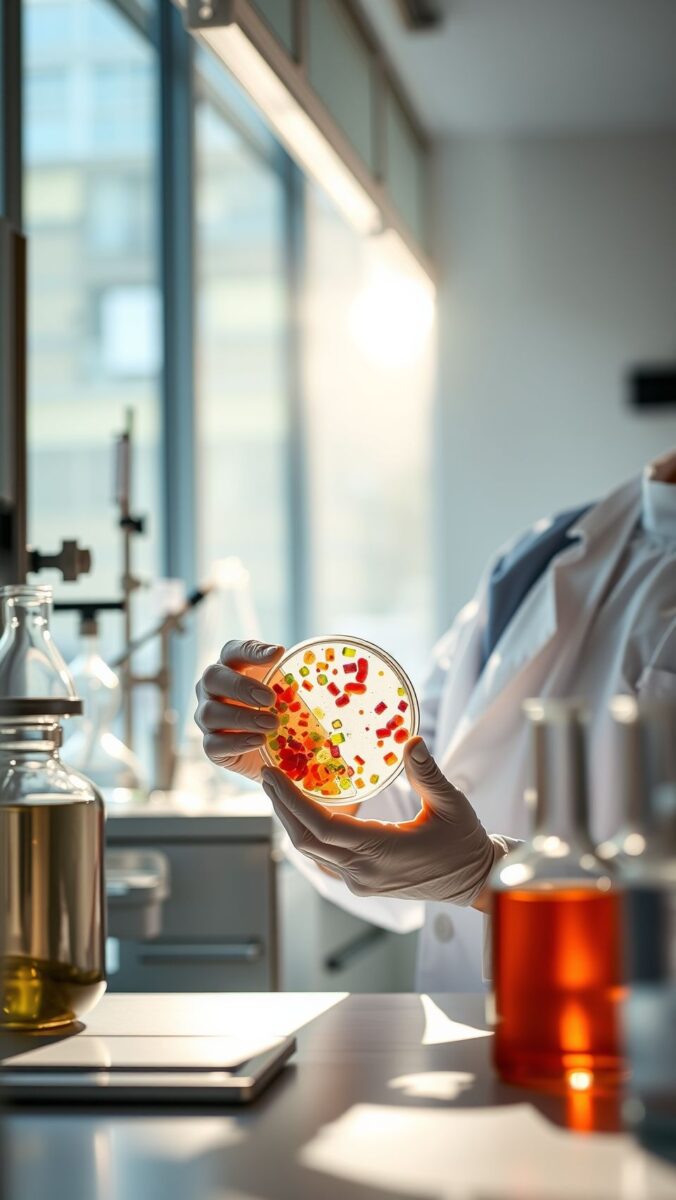

Points à retenir dans cet article
- Comprendre les bases essentielles de la nutrition et l’importance des macronutriments et micronutriments.
- Des conseils pratiques pour équilibrer votre alimentation au quotidien.
- Des recettes simples et saines à intégrer facilement dans votre routine alimentaire.
- La démystification de mythes courants autour de la nutrition et des régimes alimentaires.
Comprendre les bases de la nutrition
La nutrition est un processus fondamental pour notre corps. C’est elle qui permet à notre organisme d’utiliser les aliments pour se nourrir, se développer et fonctionner. Cela englobe une vaste gamme de nutriments, dont les macronutriments et micronutriments, tous indispensables au bon fonctionnement du corps.
Les macronutriments
Les macronutriments sont des nutriments nécessaires en grande quantité pour assurer le bon fonctionnement du corps. Ils se divisent en trois catégories : les protéines, les glucides et les lipides. Chaque catégorie a un rôle précis :
- Protéines : Elles sont cruciales pour la construction et la réparation des tissus corporels.
- Glucides : Ils fournissent de l’énergie au corps, en particulier pour les activités physiques.
- Lipides : Les graisses sont essentielles à l’absorption des vitamines et à la production d’hormones.
Les micronutriments
Bien que nécessaires en plus petites quantités, les micronutriments sont tout aussi importants pour le bon fonctionnement de notre organisme. Les vitamines et minéraux, tels que la vitamine C ou le calcium, interviennent dans de nombreuses fonctions corporelles, du système immunitaire à la santé des os.
Conseils pratiques pour une alimentation équilibrée
Pour adopter une alimentation saine et équilibrée, il existe plusieurs règles simples à suivre. Voici quelques conseils qui vous aideront à faire les bons choix alimentaires au quotidien :
- Consommez des fruits et légumes variés : Essayez d’inclure une variété de fruits et légumes dans votre alimentation quotidienne. Ils sont riches en vitamines, minéraux et fibres.
- Privilégiez les protéines maigres : Le poulet, le poisson, et les légumineuses sont d’excellentes sources de protéines sans trop de graisses saturées.
- Limitez les sucres ajoutés : Les aliments riches en sucres raffinés doivent être consommés avec modération pour éviter les pics de glycémie.
- Buvez beaucoup d’eau : Une bonne hydratation est essentielle pour le bon fonctionnement de l’organisme, alors n’oubliez pas de boire suffisamment chaque jour.
Recettes saines et simples à préparer
Pour intégrer une bonne nutrition dans votre quotidien, rien de mieux que de cuisiner soi-même. Voici une idée de recette simple et saine, à la fois équilibrée et savoureuse :
Salade de quinoa aux légumes grillés
- 200g de quinoa
- 1 courgette
- 1 poivron rouge
- 100g de feta
Suivez ces étapes pour réaliser cette recette :
- Cuire le quinoa selon les instructions du paquet.
- Griller les légumes dans une poêle avec un peu d’huile d’olive.
- Mélanger tous les ingrédients dans un saladier et ajouter la feta émiettée.
Cette recette est non seulement riche en protéines végétales, mais aussi pleine de vitamines, idéale pour un repas léger et nutritif.
Mythes et réalités sur la nutrition
Il existe une multitude de mythes concernant la nutrition. Voici quelques idées reçues que je souhaite démystifier :
Faut-il éviter toutes les graisses ?
Non, ce n’est pas nécessaire ! Certaines graisses, comme celles contenues dans l’avocat ou les noix, sont bénéfiques pour la santé. Elles jouent un rôle clé dans la protection de votre cœur et la régulation de votre cholestérol.
Les régimes à la mode sont-ils efficaces sur le long terme ?
Les régimes restrictifs ne sont souvent qu’une solution temporaire. Pour maintenir un poids santé et préserver votre bien-être, il est préférable d’adopter des habitudes alimentaires durables, basées sur l’équilibre et la modération.
Ressources supplémentaires
Pour ceux qui souhaitent approfondir leur connaissance sur la nutrition, voici quelques ressources utiles :
Une bonne nutrition est la base d’une bonne santé, mais pour améliorer la concentration, certains explorent aussi les effets du CBD.
- Site officiel du gouvernement français sur la nutrition et les habitudes alimentaires.
- Ressources de l’Organisation mondiale de la Santé sur la nutrition et la santé publique.
En appliquant ces conseils et en choisissant une alimentation équilibrée, vous pouvez améliorer votre santé et votre bien-être. N’oubliez pas que la clé réside dans l’équilibre alimentaire, adapté à vos besoins spécifiques.
Intégrer des super-aliments comme le gogi dans votre alimentation est une excellente façon d’améliorer votre nutrition globale.
Bien que la nutrition soit fondamentale, explorer comment le CBD peut aider à la concentration peut être une approche complémentaire.